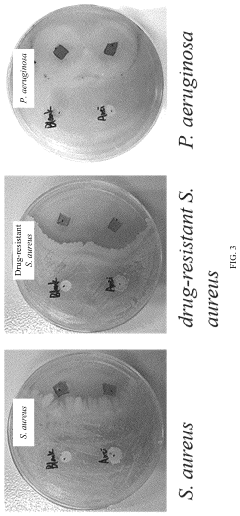

Mechanisms of Bacterial Inhibition in Antimicrobial Hydrogels
OCT 14, 20259 MIN READ
Generate Your Research Report Instantly with AI Agent
Patsnap Eureka helps you evaluate technical feasibility & market potential.
Antimicrobial Hydrogel Development History and Objectives
Antimicrobial hydrogels have evolved significantly since their conceptual inception in the mid-20th century. The initial development phase began in the 1960s with pioneering work on hydrophilic polymer networks capable of absorbing large quantities of water. These early hydrogels, however, lacked intentional antimicrobial properties and were primarily designed for applications in wound dressings and controlled drug delivery systems.
The 1980s marked a pivotal shift with the emergence of the first generation of antimicrobial hydrogels, which incorporated conventional antibiotics within their polymer matrices. This approach provided a platform for sustained release of antimicrobial agents, addressing the growing concern of bacterial infections in medical settings. However, these systems faced challenges related to burst release profiles and limited efficacy duration.
A significant technological advancement occurred in the late 1990s with the development of intrinsically antimicrobial hydrogels, where the polymer backbone itself possessed antimicrobial properties. This innovation eliminated the need for additional antimicrobial agents and reduced concerns about depletion of active compounds over time.
The early 2000s witnessed the integration of nanotechnology with hydrogel science, leading to the creation of nanocomposite antimicrobial hydrogels. These materials incorporated metal nanoparticles (particularly silver, copper, and zinc oxide) that exhibited broad-spectrum antimicrobial activity through multiple mechanisms of action, significantly enhancing their efficacy against resistant bacterial strains.
Recent developments from 2010 onwards have focused on smart antimicrobial hydrogels with stimuli-responsive properties. These advanced materials can modulate their antimicrobial activity in response to environmental triggers such as pH, temperature, or the presence of specific bacterial enzymes, enabling targeted and on-demand bacterial inhibition.
The current technological trajectory aims to develop next-generation antimicrobial hydrogels with several key objectives: enhancing the fundamental understanding of bacterial inhibition mechanisms at the molecular level; creating systems with prolonged antimicrobial efficacy to address persistent infections; developing biocompatible formulations with minimal cytotoxicity to host tissues; designing materials capable of combating multidrug-resistant bacterial strains; and establishing sustainable production methods using renewable resources.
Additionally, there is growing interest in developing antimicrobial hydrogels that can simultaneously promote tissue regeneration while preventing infection, particularly for applications in chronic wound management and tissue engineering. This dual-functionality approach represents a paradigm shift from traditional antimicrobial strategies focused solely on bacterial eradication.
The evolution of this field reflects a progressive transition from simple drug-eluting systems to sophisticated biomaterials with intrinsic antimicrobial properties and intelligent response capabilities, driven by the urgent global need to address antimicrobial resistance and healthcare-associated infections.
The 1980s marked a pivotal shift with the emergence of the first generation of antimicrobial hydrogels, which incorporated conventional antibiotics within their polymer matrices. This approach provided a platform for sustained release of antimicrobial agents, addressing the growing concern of bacterial infections in medical settings. However, these systems faced challenges related to burst release profiles and limited efficacy duration.
A significant technological advancement occurred in the late 1990s with the development of intrinsically antimicrobial hydrogels, where the polymer backbone itself possessed antimicrobial properties. This innovation eliminated the need for additional antimicrobial agents and reduced concerns about depletion of active compounds over time.
The early 2000s witnessed the integration of nanotechnology with hydrogel science, leading to the creation of nanocomposite antimicrobial hydrogels. These materials incorporated metal nanoparticles (particularly silver, copper, and zinc oxide) that exhibited broad-spectrum antimicrobial activity through multiple mechanisms of action, significantly enhancing their efficacy against resistant bacterial strains.
Recent developments from 2010 onwards have focused on smart antimicrobial hydrogels with stimuli-responsive properties. These advanced materials can modulate their antimicrobial activity in response to environmental triggers such as pH, temperature, or the presence of specific bacterial enzymes, enabling targeted and on-demand bacterial inhibition.
The current technological trajectory aims to develop next-generation antimicrobial hydrogels with several key objectives: enhancing the fundamental understanding of bacterial inhibition mechanisms at the molecular level; creating systems with prolonged antimicrobial efficacy to address persistent infections; developing biocompatible formulations with minimal cytotoxicity to host tissues; designing materials capable of combating multidrug-resistant bacterial strains; and establishing sustainable production methods using renewable resources.
Additionally, there is growing interest in developing antimicrobial hydrogels that can simultaneously promote tissue regeneration while preventing infection, particularly for applications in chronic wound management and tissue engineering. This dual-functionality approach represents a paradigm shift from traditional antimicrobial strategies focused solely on bacterial eradication.
The evolution of this field reflects a progressive transition from simple drug-eluting systems to sophisticated biomaterials with intrinsic antimicrobial properties and intelligent response capabilities, driven by the urgent global need to address antimicrobial resistance and healthcare-associated infections.
Clinical Demand Analysis for Antimicrobial Hydrogel Applications
The healthcare sector demonstrates a significant and growing demand for antimicrobial hydrogels across multiple clinical applications. Hospital-acquired infections (HAIs) represent a substantial burden on healthcare systems worldwide, with approximately 1.7 million HAIs occurring annually in the United States alone, resulting in nearly 99,000 deaths and adding $20 billion to healthcare costs. This pressing challenge creates a substantial market opportunity for advanced wound care solutions incorporating antimicrobial hydrogels.
Chronic wound management constitutes a primary clinical application area, with diabetic foot ulcers, pressure ulcers, and venous leg ulcers affecting over 6.5 million patients in the United States. These conditions often require prolonged treatment due to bacterial colonization and biofilm formation that impede healing processes. Antimicrobial hydrogels offer significant advantages in this context by providing sustained antimicrobial activity while maintaining a moist wound environment conducive to healing.
Surgical site infections (SSIs) represent another critical application domain, occurring in 2-5% of all surgical procedures. The financial impact of SSIs is substantial, with each infection adding approximately $20,000 to hospital costs. Antimicrobial hydrogels designed for surgical wound management can significantly reduce infection rates through controlled release of antimicrobial agents directly at the surgical site.
Burns treatment presents unique challenges that antimicrobial hydrogels are particularly well-suited to address. The compromised skin barrier in burn patients creates high susceptibility to infection, with over 40% of burn-related deaths associated with infection complications. Hydrogels provide cooling effects, pain relief, and antimicrobial protection while facilitating autolytic debridement of necrotic tissue.
The dental and oral care market also demonstrates growing demand for antimicrobial hydrogels in treating periodontal disease, which affects nearly 50% of adults worldwide. Hydrogel delivery systems can maintain therapeutic concentrations of antimicrobial agents in the periodontal pocket, improving treatment efficacy compared to conventional approaches.
Implant-associated infections, occurring in 1-4% of joint replacements and up to 10% of cardiovascular implants, represent a specialized application area where antimicrobial hydrogel coatings can significantly reduce biofilm formation on medical devices. The economic burden of these infections is substantial, often requiring implant removal and replacement.
Market analysis indicates the global antimicrobial wound dressing market, which includes hydrogels, is projected to reach $3.5 billion by 2025, growing at a CAGR of 6.7%. This growth is driven by increasing prevalence of chronic wounds, rising surgical procedures, and growing awareness of infection control practices in healthcare settings.
Chronic wound management constitutes a primary clinical application area, with diabetic foot ulcers, pressure ulcers, and venous leg ulcers affecting over 6.5 million patients in the United States. These conditions often require prolonged treatment due to bacterial colonization and biofilm formation that impede healing processes. Antimicrobial hydrogels offer significant advantages in this context by providing sustained antimicrobial activity while maintaining a moist wound environment conducive to healing.
Surgical site infections (SSIs) represent another critical application domain, occurring in 2-5% of all surgical procedures. The financial impact of SSIs is substantial, with each infection adding approximately $20,000 to hospital costs. Antimicrobial hydrogels designed for surgical wound management can significantly reduce infection rates through controlled release of antimicrobial agents directly at the surgical site.
Burns treatment presents unique challenges that antimicrobial hydrogels are particularly well-suited to address. The compromised skin barrier in burn patients creates high susceptibility to infection, with over 40% of burn-related deaths associated with infection complications. Hydrogels provide cooling effects, pain relief, and antimicrobial protection while facilitating autolytic debridement of necrotic tissue.
The dental and oral care market also demonstrates growing demand for antimicrobial hydrogels in treating periodontal disease, which affects nearly 50% of adults worldwide. Hydrogel delivery systems can maintain therapeutic concentrations of antimicrobial agents in the periodontal pocket, improving treatment efficacy compared to conventional approaches.
Implant-associated infections, occurring in 1-4% of joint replacements and up to 10% of cardiovascular implants, represent a specialized application area where antimicrobial hydrogel coatings can significantly reduce biofilm formation on medical devices. The economic burden of these infections is substantial, often requiring implant removal and replacement.
Market analysis indicates the global antimicrobial wound dressing market, which includes hydrogels, is projected to reach $3.5 billion by 2025, growing at a CAGR of 6.7%. This growth is driven by increasing prevalence of chronic wounds, rising surgical procedures, and growing awareness of infection control practices in healthcare settings.
Current Bacterial Inhibition Mechanisms and Limitations
Antimicrobial hydrogels employ several distinct mechanisms to inhibit bacterial growth and proliferation. The primary mechanism involves the release of antimicrobial agents embedded within the hydrogel matrix. These agents include conventional antibiotics, metal nanoparticles (particularly silver, copper, and zinc), quaternary ammonium compounds, and natural antimicrobials such as essential oils and peptides. The controlled release kinetics of these agents allows for sustained antibacterial activity over extended periods, which represents a significant advantage over traditional delivery systems.
Contact-killing mechanisms constitute another important approach, where the hydrogel surface is functionalized with cationic polymers or peptides that disrupt bacterial cell membranes upon contact. This disruption leads to cellular content leakage and eventual bacterial death. The effectiveness of this mechanism depends largely on the surface charge density and the accessibility of functional groups on the hydrogel surface.
Anti-adhesion strategies prevent bacterial colonization by creating surfaces that resist protein adsorption and subsequent bacterial attachment. This is typically achieved through hydrophilic polymer coatings or micro-patterned surfaces that physically impede bacterial adhesion. PEG-based hydrogels are particularly effective in this regard due to their highly hydrated structure.
Reactive oxygen species (ROS) generation represents a more aggressive approach, where hydrogels incorporate photosensitizers or catalytic components that produce ROS upon stimulation. These highly reactive species cause oxidative damage to bacterial cell components, leading to broad-spectrum antimicrobial activity.
Despite these advances, current antimicrobial hydrogels face several limitations. The development of bacterial resistance remains a significant concern, particularly with antibiotic-releasing systems. Bacteria can adapt through various mechanisms, including efflux pumps, enzymatic degradation, and biofilm formation, which significantly reduce antimicrobial efficacy over time.
Biocompatibility issues present another challenge, as many antimicrobial agents that effectively kill bacteria may also exhibit cytotoxicity toward mammalian cells. This toxicity limits their application in medical devices and wound dressings where tissue integration is crucial.
The stability and durability of antimicrobial hydrogels in physiological environments often fall short of requirements for long-term applications. Hydrolytic degradation, enzymatic breakdown, and mechanical stress can compromise the structural integrity of hydrogels and accelerate the release of antimicrobial agents, leading to reduced longevity of antibacterial effects.
Additionally, the efficacy of current hydrogel systems against biofilm-forming bacteria remains limited. Mature biofilms create protective environments that significantly reduce the penetration and effectiveness of antimicrobial agents. The extracellular polymeric substances (EPS) produced by biofilm communities act as diffusion barriers and can bind antimicrobial agents before they reach bacterial cells.
Contact-killing mechanisms constitute another important approach, where the hydrogel surface is functionalized with cationic polymers or peptides that disrupt bacterial cell membranes upon contact. This disruption leads to cellular content leakage and eventual bacterial death. The effectiveness of this mechanism depends largely on the surface charge density and the accessibility of functional groups on the hydrogel surface.
Anti-adhesion strategies prevent bacterial colonization by creating surfaces that resist protein adsorption and subsequent bacterial attachment. This is typically achieved through hydrophilic polymer coatings or micro-patterned surfaces that physically impede bacterial adhesion. PEG-based hydrogels are particularly effective in this regard due to their highly hydrated structure.
Reactive oxygen species (ROS) generation represents a more aggressive approach, where hydrogels incorporate photosensitizers or catalytic components that produce ROS upon stimulation. These highly reactive species cause oxidative damage to bacterial cell components, leading to broad-spectrum antimicrobial activity.
Despite these advances, current antimicrobial hydrogels face several limitations. The development of bacterial resistance remains a significant concern, particularly with antibiotic-releasing systems. Bacteria can adapt through various mechanisms, including efflux pumps, enzymatic degradation, and biofilm formation, which significantly reduce antimicrobial efficacy over time.
Biocompatibility issues present another challenge, as many antimicrobial agents that effectively kill bacteria may also exhibit cytotoxicity toward mammalian cells. This toxicity limits their application in medical devices and wound dressings where tissue integration is crucial.
The stability and durability of antimicrobial hydrogels in physiological environments often fall short of requirements for long-term applications. Hydrolytic degradation, enzymatic breakdown, and mechanical stress can compromise the structural integrity of hydrogels and accelerate the release of antimicrobial agents, leading to reduced longevity of antibacterial effects.
Additionally, the efficacy of current hydrogel systems against biofilm-forming bacteria remains limited. Mature biofilms create protective environments that significantly reduce the penetration and effectiveness of antimicrobial agents. The extracellular polymeric substances (EPS) produced by biofilm communities act as diffusion barriers and can bind antimicrobial agents before they reach bacterial cells.
Established Bacterial Inhibition Strategies in Hydrogel Systems
01 Silver-based antimicrobial hydrogels
Silver nanoparticles and silver compounds are incorporated into hydrogel matrices to create effective antimicrobial systems. These silver-based hydrogels exhibit broad-spectrum antibacterial activity against both gram-positive and gram-negative bacteria. The controlled release of silver ions from the hydrogel matrix provides sustained antimicrobial action while maintaining biocompatibility. These formulations are particularly effective for wound dressing applications where bacterial inhibition is crucial for proper healing.- Silver-based antimicrobial hydrogels: Silver nanoparticles and silver compounds can be incorporated into hydrogel matrices to create effective antimicrobial systems. These silver-based hydrogels exhibit broad-spectrum antibacterial activity against both gram-positive and gram-negative bacteria. The controlled release of silver ions from the hydrogel matrix provides sustained antimicrobial action, making these materials suitable for wound dressings and medical device coatings. The antimicrobial efficacy can be enhanced by optimizing the silver content and distribution within the hydrogel network.
- Quaternary ammonium compound-based hydrogels: Hydrogels containing quaternary ammonium compounds (QACs) demonstrate potent antibacterial properties through disruption of bacterial cell membranes. These cationic compounds can be chemically bound to the hydrogel network or incorporated as mobile agents within the matrix. QAC-based hydrogels are particularly effective against biofilm formation and can maintain their antimicrobial activity over extended periods. The positive charge of these compounds attracts negatively charged bacterial cell walls, leading to cell lysis and bacterial inhibition.
- Natural polymer-based antimicrobial hydrogels: Hydrogels formulated with natural polymers such as chitosan, alginate, and cellulose derivatives exhibit inherent antimicrobial properties. These biopolymer-based hydrogels can be further enhanced with plant extracts or essential oils to broaden their antimicrobial spectrum. The biodegradability and biocompatibility of these materials make them suitable for biomedical applications including wound healing and drug delivery systems. The antimicrobial action often involves multiple mechanisms including bacterial membrane disruption and metabolic interference.
- Photodynamic antimicrobial hydrogels: Hydrogels incorporating photosensitizer compounds can generate reactive oxygen species upon light exposure, resulting in bacterial inhibition. These photodynamic antimicrobial hydrogels can be activated using specific wavelengths of light to provide on-demand antimicrobial action. The localized production of reactive oxygen species damages bacterial cell components including membranes, proteins, and nucleic acids. This approach offers the advantage of spatial and temporal control over antimicrobial activity, reducing the risk of developing bacterial resistance.
- Antibiotic-loaded hydrogel delivery systems: Hydrogels can serve as effective carriers for controlled release of conventional antibiotics, enhancing their efficacy while reducing systemic toxicity. These systems allow for sustained local delivery of antimicrobial agents directly at infection sites. The hydrogel matrix can be designed with specific degradation profiles to optimize antibiotic release kinetics. Additionally, stimuli-responsive hydrogels can be engineered to release antibiotics in response to environmental triggers such as pH changes, temperature, or the presence of bacterial enzymes, providing smart antimicrobial systems.
02 Natural polymer-based antimicrobial hydrogels
Hydrogels formulated with natural polymers such as chitosan, alginate, and cellulose derivatives demonstrate inherent antimicrobial properties. These biopolymers can be modified or combined with other active ingredients to enhance their bacterial inhibition capabilities. The biodegradable and biocompatible nature of these natural polymer hydrogels makes them suitable for various biomedical applications including wound healing, drug delivery, and tissue engineering where bacterial control is essential.Expand Specific Solutions03 Quaternary ammonium compound-containing hydrogels
Hydrogels incorporating quaternary ammonium compounds (QACs) exhibit strong antimicrobial activity through disruption of bacterial cell membranes. These cationic compounds can be chemically bound to the hydrogel network or incorporated as releasable agents. QAC-containing hydrogels demonstrate effective bacterial inhibition against a wide range of pathogens while maintaining the moisture-retention properties of the hydrogel. These formulations are particularly useful in personal care products, medical devices, and surface coatings requiring long-lasting antimicrobial protection.Expand Specific Solutions04 Antibiotic-loaded hydrogel systems
Hydrogels can be formulated as carriers for conventional antibiotics, providing controlled release and targeted delivery. These systems allow for sustained release of antibiotics at the site of infection, maintaining effective concentrations for bacterial inhibition while reducing systemic exposure. The hydrogel matrix protects the antibiotic from degradation and can be designed to respond to specific triggers such as pH, temperature, or enzymatic activity for smart release. This approach is particularly valuable for treating localized infections and preventing bacterial biofilm formation on medical devices.Expand Specific Solutions05 Stimuli-responsive antimicrobial hydrogels
Advanced hydrogel systems that respond to environmental stimuli such as pH, temperature, light, or specific enzymes to trigger or enhance antimicrobial activity. These smart hydrogels can change their properties in response to bacterial presence, releasing antimicrobial agents on demand or altering their structure to directly inhibit bacterial growth. Some formulations incorporate photosensitizers that generate reactive oxygen species upon light exposure, providing on-demand bacterial inhibition. This responsive approach minimizes unnecessary antimicrobial release, reducing the risk of resistance development while maintaining effective bacterial control.Expand Specific Solutions
Leading Research Institutions and Companies in Antimicrobial Hydrogels
The antimicrobial hydrogel market is currently in a growth phase, with increasing applications in wound care, drug delivery, and medical devices. The global market size is estimated to reach $3.5 billion by 2027, driven by rising prevalence of chronic wounds and hospital-acquired infections. Academic institutions dominate the research landscape, with University of Delaware, Zhejiang University, and McMaster University leading fundamental research on bacterial inhibition mechanisms. Commercial players like Bausch & Lomb, First Water Ltd., and Blueberry Therapeutics are advancing the technology toward clinical applications. The technology is approaching maturity in basic wound care applications, while more sophisticated drug delivery systems remain in early development stages. Research collaborations between academia and industry, particularly involving CSIR and Nanyang Technological University, are accelerating innovation in this field.
Zhejiang University
Technical Solution: Zhejiang University has pioneered antimicrobial hydrogels utilizing a "trap and kill" mechanism that combines physical bacterial entrapment with chemical elimination. Their hydrogels feature a microporous structure with positively charged surfaces that attract negatively charged bacterial cell walls, immobilizing pathogens within the matrix[2]. Once trapped, integrated antimicrobial peptides disrupt bacterial membranes through barrel-stave, carpet, or toroidal pore mechanisms[4]. The university has also developed temperature-responsive hydrogels containing N-isopropylacrylamide that undergo phase transition at physiological temperatures, enhancing bacterial contact and antimicrobial efficacy[6]. Their recent innovation includes self-healing antimicrobial hydrogels with dynamic imine bond crosslinking, allowing for sustained antimicrobial activity even after mechanical damage. These hydrogels incorporate metal-organic frameworks (MOFs) as nanocarriers for controlled release of antibiotics, preventing initial burst release and maintaining effective antimicrobial concentrations over extended periods while minimizing potential resistance development.
Strengths: Self-healing properties ensure continuous antimicrobial barrier integrity; controlled release systems maintain therapeutic concentrations while reducing dosing frequency; biodegradable compositions eliminate need for removal. Weaknesses: Complex synthesis processes may limit large-scale manufacturing; potential for incomplete degradation of synthetic components; some formulations show reduced efficacy against gram-positive bacteria compared to gram-negative strains.
The Regents of the University of California
Technical Solution: The University of California has developed innovative antimicrobial hydrogels that employ multiple bacterial inhibition mechanisms. Their technology utilizes quaternary ammonium compound (QAC)-functionalized hydrogels that disrupt bacterial cell membranes through electrostatic interactions between positively charged QACs and negatively charged bacterial membranes[1]. Additionally, they've engineered hydrogels incorporating silver nanoparticles that provide sustained release of silver ions, which interfere with bacterial DNA replication and disrupt cellular respiration[3]. Their research also includes photodynamic antimicrobial hydrogels containing photosensitizers that generate reactive oxygen species upon light exposure, causing oxidative damage to bacterial cells[5]. The university has further developed enzyme-responsive hydrogels that release antimicrobial agents specifically in the presence of bacterial enzymes, allowing for targeted delivery at infection sites while minimizing systemic exposure and potential resistance development.
Strengths: Multi-modal antimicrobial action reduces likelihood of bacterial resistance; controlled release systems allow for sustained antimicrobial activity; biocompatible materials suitable for medical applications. Weaknesses: Some formulations require external stimuli (like light) limiting application scenarios; potential cytotoxicity concerns with certain antimicrobial agents; manufacturing complexity may increase production costs.
Key Patents and Research on Antimicrobial Hydrogel Mechanisms
Long-lasting hydrogel for use against drug-resistant bacteria and preparation method and use thereof
PatentPendingUS20230381325A1
Innovation
- A phytic acid and honey-modified polyvinyl alcohol (PVA)-based hydrogel is developed, utilizing esterification reactions, hydrogen bonds, and electrostatic interactions to create a crosslinked structure that enhances mechanical properties and antimicrobial efficacy against Staphylococcus aureus and Pseudomonas aeruginosa, including drug-resistant strains.
Antibacterial hydrogel composition and application thereof
PatentPendingIN708KOL2013A
Innovation
- An antimicrobial hydrogel formulation using Abroma augusta Linn. stem extract to reduce and stabilize silver nanoparticles in the absence of external agents, incorporating Vitamin E for enhanced stability and skin benefits, providing broad-spectrum antimicrobial activity and moisture balance.
Biocompatibility and Safety Considerations
The biocompatibility and safety profile of antimicrobial hydrogels represent critical factors determining their clinical applicability and commercial viability. When developing these materials for medical applications, researchers must consider both short-term and long-term biological interactions with host tissues. Current evidence suggests that while many antimicrobial hydrogels demonstrate excellent bacterial inhibition properties, their safety profiles vary significantly depending on their composition and mechanism of action.
Cytotoxicity assessment stands as a primary concern, particularly for hydrogels incorporating metal nanoparticles or quaternary ammonium compounds. Recent studies indicate that silver nanoparticle-loaded hydrogels may exhibit dose-dependent toxicity to mammalian cells, with potential accumulation in organs following prolonged exposure. Conversely, peptide-based antimicrobial hydrogels generally demonstrate superior biocompatibility profiles, with selective toxicity toward bacterial membranes while sparing mammalian cell structures.
Inflammatory responses represent another critical safety consideration. Some antimicrobial agents can trigger localized inflammation, potentially compromising wound healing processes or exacerbating existing conditions. Advanced hydrogel formulations incorporating anti-inflammatory components have shown promise in mitigating these effects, creating dual-functional materials that both combat infection and support tissue regeneration.
Biodegradation pathways and metabolite safety require thorough investigation, particularly for implantable or long-term use hydrogels. The degradation products must be non-toxic and readily cleared from the body. Synthetic polymer-based hydrogels often present greater challenges in this regard compared to naturally derived materials like alginate or chitosan, which typically follow established metabolic pathways.
Regulatory considerations for antimicrobial hydrogels have become increasingly stringent, with authorities requiring comprehensive safety data packages. The FDA and EMA have established specific guidelines for antimicrobial materials, focusing on leachable compounds, long-term stability, and potential for antimicrobial resistance development. These regulatory frameworks significantly impact development timelines and commercialization strategies.
Emerging research focuses on developing predictive in vitro models that better simulate in vivo conditions, potentially reducing animal testing requirements while improving safety prediction accuracy. Organ-on-chip technologies and 3D tissue models represent promising approaches for evaluating antimicrobial hydrogel safety in physiologically relevant environments, potentially accelerating development timelines while enhancing safety profiles.
Cytotoxicity assessment stands as a primary concern, particularly for hydrogels incorporating metal nanoparticles or quaternary ammonium compounds. Recent studies indicate that silver nanoparticle-loaded hydrogels may exhibit dose-dependent toxicity to mammalian cells, with potential accumulation in organs following prolonged exposure. Conversely, peptide-based antimicrobial hydrogels generally demonstrate superior biocompatibility profiles, with selective toxicity toward bacterial membranes while sparing mammalian cell structures.
Inflammatory responses represent another critical safety consideration. Some antimicrobial agents can trigger localized inflammation, potentially compromising wound healing processes or exacerbating existing conditions. Advanced hydrogel formulations incorporating anti-inflammatory components have shown promise in mitigating these effects, creating dual-functional materials that both combat infection and support tissue regeneration.
Biodegradation pathways and metabolite safety require thorough investigation, particularly for implantable or long-term use hydrogels. The degradation products must be non-toxic and readily cleared from the body. Synthetic polymer-based hydrogels often present greater challenges in this regard compared to naturally derived materials like alginate or chitosan, which typically follow established metabolic pathways.
Regulatory considerations for antimicrobial hydrogels have become increasingly stringent, with authorities requiring comprehensive safety data packages. The FDA and EMA have established specific guidelines for antimicrobial materials, focusing on leachable compounds, long-term stability, and potential for antimicrobial resistance development. These regulatory frameworks significantly impact development timelines and commercialization strategies.
Emerging research focuses on developing predictive in vitro models that better simulate in vivo conditions, potentially reducing animal testing requirements while improving safety prediction accuracy. Organ-on-chip technologies and 3D tissue models represent promising approaches for evaluating antimicrobial hydrogel safety in physiologically relevant environments, potentially accelerating development timelines while enhancing safety profiles.
Regulatory Pathway for Medical-Grade Antimicrobial Hydrogels
The regulatory landscape for medical-grade antimicrobial hydrogels is complex and multifaceted, requiring careful navigation to ensure successful market entry. These products typically fall under the classification of medical devices or combination products, depending on their primary mode of action and intended use.
In the United States, the Food and Drug Administration (FDA) oversees the approval process through different pathways. Antimicrobial hydrogels may be regulated under the Center for Devices and Radiological Health (CDRH) if the primary function is mechanical (such as wound covering), or under the Center for Drug Evaluation and Research (CDER) if the antimicrobial action is the primary function.
The 510(k) premarket notification pathway is commonly utilized for antimicrobial hydrogels that are substantially equivalent to legally marketed devices. This requires demonstration of safety and effectiveness compared to predicate devices. For novel antimicrobial hydrogels with no substantial equivalence, the Premarket Approval (PMA) pathway becomes necessary, demanding more rigorous clinical trials.
In the European Union, the Medical Device Regulation (MDR) governs these products. Antimicrobial hydrogels typically fall under Class IIb or III, depending on their intended use and duration of contact with the body. Conformity assessment procedures include quality management system certification and technical documentation review by Notified Bodies.
Risk classification significantly impacts the regulatory pathway. Factors considered include the mechanism of bacterial inhibition, potential for antimicrobial resistance development, biocompatibility, and the intended clinical application. Products intended for use in critical applications such as implants or deep wound care face more stringent requirements.
Quality control standards are particularly important for antimicrobial hydrogels. ISO 10993 series for biocompatibility testing, ISO 11737 for sterilization validation, and specific antimicrobial efficacy testing standards must be adhered to. Manufacturers must implement robust quality management systems compliant with ISO 13485.
Post-market surveillance requirements have become increasingly stringent globally. Manufacturers must maintain vigilance systems to monitor adverse events, conduct post-market clinical follow-up studies, and submit periodic safety update reports. The unique antimicrobial properties of these hydrogels necessitate particular attention to potential development of bacterial resistance over time.
Regulatory strategies should be integrated early in product development. Engaging with regulatory authorities through pre-submission consultations can provide valuable guidance on testing requirements and approval pathways, potentially saving significant time and resources in the development process.
In the United States, the Food and Drug Administration (FDA) oversees the approval process through different pathways. Antimicrobial hydrogels may be regulated under the Center for Devices and Radiological Health (CDRH) if the primary function is mechanical (such as wound covering), or under the Center for Drug Evaluation and Research (CDER) if the antimicrobial action is the primary function.
The 510(k) premarket notification pathway is commonly utilized for antimicrobial hydrogels that are substantially equivalent to legally marketed devices. This requires demonstration of safety and effectiveness compared to predicate devices. For novel antimicrobial hydrogels with no substantial equivalence, the Premarket Approval (PMA) pathway becomes necessary, demanding more rigorous clinical trials.
In the European Union, the Medical Device Regulation (MDR) governs these products. Antimicrobial hydrogels typically fall under Class IIb or III, depending on their intended use and duration of contact with the body. Conformity assessment procedures include quality management system certification and technical documentation review by Notified Bodies.
Risk classification significantly impacts the regulatory pathway. Factors considered include the mechanism of bacterial inhibition, potential for antimicrobial resistance development, biocompatibility, and the intended clinical application. Products intended for use in critical applications such as implants or deep wound care face more stringent requirements.
Quality control standards are particularly important for antimicrobial hydrogels. ISO 10993 series for biocompatibility testing, ISO 11737 for sterilization validation, and specific antimicrobial efficacy testing standards must be adhered to. Manufacturers must implement robust quality management systems compliant with ISO 13485.
Post-market surveillance requirements have become increasingly stringent globally. Manufacturers must maintain vigilance systems to monitor adverse events, conduct post-market clinical follow-up studies, and submit periodic safety update reports. The unique antimicrobial properties of these hydrogels necessitate particular attention to potential development of bacterial resistance over time.
Regulatory strategies should be integrated early in product development. Engaging with regulatory authorities through pre-submission consultations can provide valuable guidance on testing requirements and approval pathways, potentially saving significant time and resources in the development process.
Unlock deeper insights with Patsnap Eureka Quick Research — get a full tech report to explore trends and direct your research. Try now!
Generate Your Research Report Instantly with AI Agent
Supercharge your innovation with Patsnap Eureka AI Agent Platform!